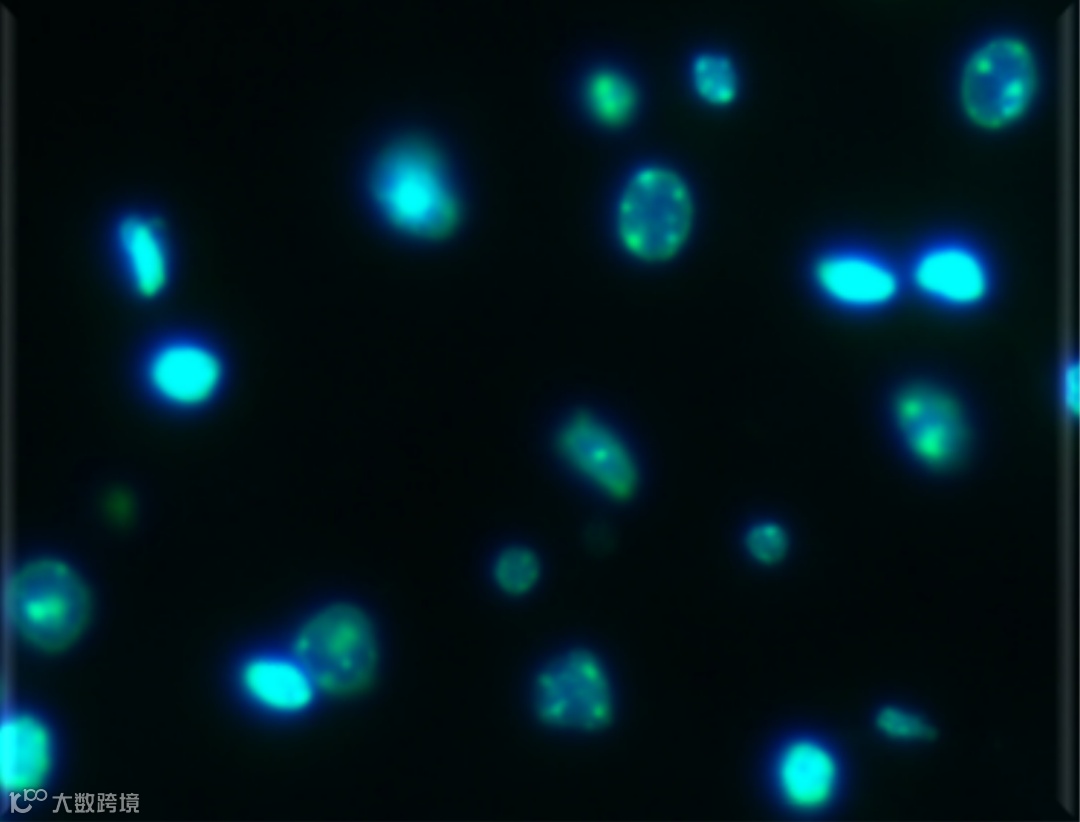

木木西里出品
光学显微镜,一直是研究微观领域不可或缺的基础设备,即便是在有更高放大倍率的扫描电子显微镜、透射电子显微镜、扫描隧道显微镜的今天,光学显微镜仍然凭借其操作方便迅速、无需对样品做过多处理、成像模式丰富、且支持图像分析处理、价格更低的特点而稳据科研一席之地。
在高中、大学,科学研究所常常都有它们的身影。小到微观世界的入门,大到生物分子、工业材料的科研工作,显微镜都是必备的一款基础且重要的仪器。
这样一款几乎科研人员必备的仪器,自诞生发展到如今,不过400多年的时间。

大约在500年之前,简单的玻璃放大镜被发明出来。
这种简易的放大镜即是大家小时候都玩儿过的、汇聚阳光、中间比边缘厚的玻璃凸透镜。将放大镜放于标本与眼晴之间即可进行调焦。这种“简单显微镜”可通知过增加视角将图像放大并成于视网膜上。

1600年,通过Anton vonLeeuwenhoek(即高中生物课本上提及的安东·冯·列文虎克)的努力使该类简单显微镜(或称之为放大玻璃)的性能达到了最完善的状态。这种简单显微镜可用来观单细胞的动物及一些较大的细菌。由一个十分靠近人眼的放大镜将标本成像成于标本同一边,该图像看起来距人眼大约为10英寸远。该像为虚像,不能被胶片捕获。

自1600年以后,借荷兰Janssen兄弟及意大利伽利略的努力,复式显微镜被发明出来。这种显微镜最简单的形式由两片凸透镜组成,一片为物镜,靠近标本,一片为目镜,靠近使用者的眼睛。复式显微镜分两步放大。物镜将一放大的图象成于镜体筒中,目镜将物镜投入的图象再放大,最终成像于我们的视网膜上。

但是早期影像技术还未起步,使得显微镜下的微观世界只能即时观察,若想把看到的微观世界呈现出来,与他人进行沟通交流,就需通过笔、纸把观察到的影像,以临摹的方式绘画出来,因此绘画就成了当时微观学工作者的一项必备技能。而如何能将显微镜更方便的呈现出来,也成了显微镜在接下来的发展中必须要解决的一个问题。
同时,因为单目显微镜仅支持单眼对准目镜观察,观察者容易眼睛疲劳,这也成为了显微镜发展面临的第二个问题。
300年后,1879年,爱迪生发明了电灯。电灯的出现使得显微镜的照明得到大幅度改善,特别是光源的亮度可以灵活调节。新型光源的发明刺激了显微镜的发展,几年之后,德国蔡司光学显微镜厂中的一位叫柯勒的工程师,发明了柯勒照明-利用分光棱镜将物镜上传来的光信号一分为二,使用者可以通过两只眼睛进行观察,这样便大幅减轻了眼睛负担,提高了观察的舒适度。同年,德国蔡司公司便发明了双目显微镜,并逐渐代单目显微的使用。
显微镜在20世纪70年代获得广泛应用。至21世纪初期,进入了使用高峰。光学成像效果取得重大进展之后,人们将显微镜改善的重点放在了显微图像的获取技术上。人们把双目显微镜的光路信号进行再次分光,形成三目观察筒,然后将摄像采集装置安装于三目观察筒上以获得显微图像。此后显微影像照片逐浙成人们获取原始信息的重要手段。相比之前提及的显微绘画,这种获取显微图像的方式更精准、更高效、更先进。
我国制造光学显微镜的历史有近70年,最早生产的时间是在抗战时期,由严济慈、钱临照、林友苞等人在云南建立了一小型光学车间,生产显微镜分送抗日后方教学、医学和工程建设单位使用。解放后,国内的重庆光学厂技术实力雄厚且鉴于社会主义制度的优越性,光学显微镜国营大小厂之间无技术或是生产的秘密性,很快国内便涌现除了诸多优越的光学厂,诸如上海光学厂、南京江南光学厂、重庆光学仪器厂等最有实力,广州光学厂、桂林光学厂等也有一定的知名度。
上海光学仪器厂,素有“东方蔡司”之称,曾经是国内最知名的光学厂,并曾先后与德国蔡司-欧波同(ZEISS-OPTON)、徕卡(LEICA)等国际著名光学公司合作生产各类精密光学仪器,奠定了国家光学工业的系列化。后来因诸多内外部原因,解体重组,让人惋惜。直到现在,上光的显微镜到现在还被很多人使用与记起。
现如今,木木西里作为近些年起步的显微镜生产厂家,脱胎于上光,当前生产、直销适用于科研工作以及本科教学的工业非活体显微镜,可供诸多科研用户选择,服务为科研,助力科研人。


光学显微镜可粗分为生物显微镜与工业非活体显微镜,前者在生物、药学领域应用较多,主要有正置生物显微镜、倒置生物显微镜,通过增加一些其他的功能模块,还可以升级为正置荧光显微镜和倒置荧光显微镜。

而工业非活体显微镜,其分类多一些,诸如正置金相显微镜、倒置金相显微镜、专业型偏光显微镜、体视显微镜等等。因为体视显微镜的放大倍率低但景深大且成像富有立体感,体视显微镜又被称之为低倍显微镜或是宏观显微镜。

金相显微镜
主要是用来看不透明的样品,比如金属组织(铜、铸铁、合金等)、芯片半导体行业的高倍检测、光伏产品或其他不透明的材料。
分正置金相显微镜和倒置金相显微镜,区分依据主要是根据不同的样品,一般来讲做金属组织的金相分析用倒置金相显微镜;看芯片半导体之类(形状相对规整)的用正置金相显微镜。
特殊用途的显微镜,主要是用是来观察液晶、纤维等自身具有单折射性或双折性的物体,比如岩石矿石、高分子材料、淀粉偏光特性、液晶的偏光特性等。
专业的偏光显微镜只有正置型的。而且专业的偏光显微镜有一个比较显著的特征就是工作台是圆形的,可转动的。
因为倍数比较低(可视范围较大),成像比较有立体感,工作距离长(可进行镜下操作)的特点,所以经常被用作生物解剖、晶体挑选或宏观低倍观察、种子观察、植物病虫害防治、产品表面外观加工情况观察、电子行业等,用于观察体积相对大的物体。
其观察的样品,大都具有共同的特点是:样品表面不平整,倍数要求不高。
主要有两种光学系统:中央主物镜光学系统和格林诺夫光学系统。
中央主物镜光学系统
优势:光路系统中支持加一些其他的模块,如偏光模块/荧光模块(支持多种观察方式),该光学系统,分辨率高(约0.5微米,放大倍数能达到300倍)。
缺点:景深不高。
格林诺夫光学系统
优势:景深大,观察图像立体感强。
缺点:属于中低端产品,适用于宏观观察。

还有一些更为高端的显微镜,诸如超景深显微镜、超高分辨率显微镜、共聚焦显微镜等等,或是在保证放大倍数的基础上具备更大的景深,或是支持更高的分辨率(高于光学显微镜的理论分辨率极限200nm)等等,如您有光学显微镜的需求,尽情垂询木木西里官方-科研助手座机:400 677 0001。

目镜组/物镜组,放大倍数范围;
转换器孔数、物镜转换模式;
载物台移动模式;
物镜工作环境(干洗物镜OR油系物镜或其他)
物镜工作距离;
显微镜成像分辨率;
显微镜支持观察模式,诸如明场、暗场、偏光、荧光、微分干涉等等;
显微镜的成像质量、目标细节衬度等等;

图:金相组织观察

图:电子元器件观察

图:多折射性晶体观察

图:线路板观察

图:生物组织观察
图:荧光观察

木木西里主营的工业非活体显微镜主要有倒置金相显微镜、正置金相显微镜、偏光显微镜和体视显微镜。






金相显微镇主要是用来看不透明的样品,比如金属组织(铜、铸铁、合金等)、 芯片半导体行业的高倍检测,光伏产品或其他不透明的材料。一般来讲做金属组织的金相分析用倒置金相显微镜,看芯片半导体之类的用正置金相显微镜。


图:芯片/电路观基
偏光显微镜主要观察带偏光特性的样品,比如岩石矿石、高分子材料、淀粉偏光特性、液晶的偏光特性等。

体视显微镜因为倍数比较低,成像比较有立体感,工作距离长的特点,所以经常被用作生物解剖、晶体挑选或宏观低倍观察、种子观察、植物病虫害防治、产品表面外观加工情况观察、电子行业等。其观察的样品,大都具有共同的特点是:样品表面不平整,倍数要求不高。

木木西里光学显微镜工厂的员工约有1/3来自老上光,产品质量方面有传承和保障;
产品性能定位是国内中高端,价格定位相对适中,性价比较高;
支持显微镜的个性化定制服务,包括硬件和软件;
80%以上的型号均有样机,可以提供样机试用服务或者上门演示服务,用户也可以到上海、北京、西安办事处就近现场测试;
显微镜适配彩色数字成像系统,中高端成像系统自带软件,附赠自带图像拼接、景深拓展等等功能;
木木西里驻点繁多,在上海、济南、青岛、西安、徐州、杭州、天津设有办事处,这样基本可以辐射全国大部分省市,显微镜均可提供上门安装调试服务。
更多关于工业非活体显微镜的详细信息,可添加微信:13127749734(备注:工业非活体显微镜),咨询产品经理Ken。
(内容来源:木木西里)
文末说句正事



OPTIZEN 紫外可见光分光光度计——极简实验助手





